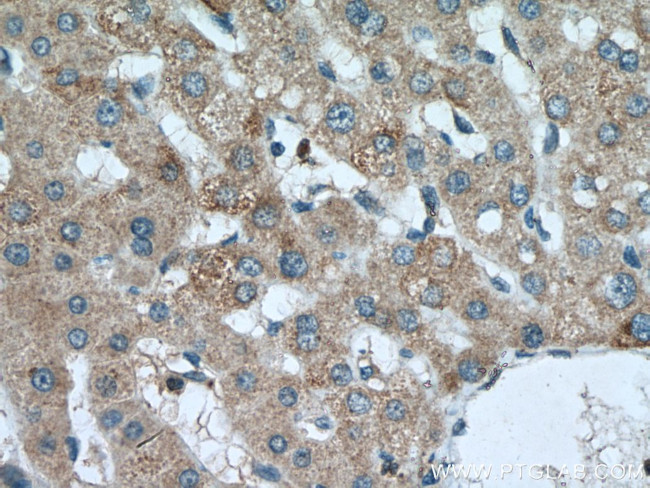
SLC25A15 Antibody in Immunohistochemistry (Paraffin) (IHC (P))

Search
Proteintech
SLC25A15 Polyclonal Antibody
{{$productOrderCtrl.translations['antibody.pdp.commerceCard.promotion.promotions']}}
{{$productOrderCtrl.translations['antibody.pdp.commerceCard.promotion.viewpromo']}}
{{$productOrderCtrl.translations['antibody.pdp.commerceCard.promotion.promocode']}}: {{promo.promoCode}} {{promo.promoTitle}} {{promo.promoDescription}}. {{$productOrderCtrl.translations['antibody.pdp.commerceCard.promotion.learnmore']}}
产品信息
15317-1-AP
种属反应
宿主/亚型
分类
类型
抗原
偶联物
形式
浓度
规格
纯化类型
保存液
内含物
保存条件
运输条件
产品详细信息
Immunogen sequence: MKSNPAIQA AIDLTAGAAG GTACVLTGQP FDTMKVKMQT FPDLYRGLTD CCLKTYSQVG FRGFYKGTSP ALIANIAENS VLFMCYGFCQ QVVRKVAGLD KQAKLSDLQN AAAGSFASAF AALVLCPTEL VKCRLQTMYE METSGKIAKS QNTVWSVIKS ILRKDGPLGF YHGLSSTLLR EVPGYFFFFG GYELSRSFFA SGRSKDELGP VPLMLSGGVG GICLWLAVYP VDCIKSRIQV LSMSGKQAGF IRTFLNVVKN EGITALYSGL KPTMIRAFPA NGALFLAYEY SRKLMMNQLE AY (1-301 aa encoded by BC002702)
靶标信息
The SLC25A15 gene encodes the mitochondrial ornithine transporter, which transports ornithine across the inner mitochondrial membrane from the cytosol to the mitochondrial matrix. This is a vital step in the urea cycle, which serves to eliminate toxic ammonium ions from the breakdown of nitrogen.
仅用于科研。不用于诊断过程。未经明确授权不得转售。
篇参考文献 (0)
生物信息学
蛋白别名: hyperammonemia-hyperornithinemia-homocitrullinuria syndrome; Mitochondrial ornithine transporter 1; ornithine carrier 1; ornithine transporter 1; ornithine transporter) member 15; ornithine transporter, mitochondrial 1; solute carrier family 25 (mitochondrial carrier; ornithine transporter) member 15; Solute carrier family 25 member 15; unnamed protein product
基因别名: Ab1-114; D13S327; D630044L02Rik; HHH; LNC-HC; ORC1; ORNT1; SLC25A15; SP1855
UniProt ID: (Human) Q9Y619, (Rat) A0A0G2K309, (Mouse) Q9WVD5
Entrez Gene ID: (Human) 10166, (Rat) 306574, (Mouse) 18408